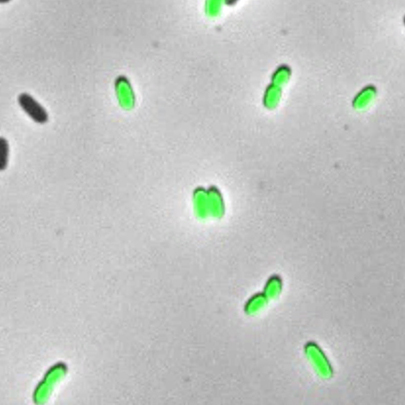

News 2019

Every year, bavarian students nominate lecturers who have excelled in teaching. At the award ceremony in the Bavarian State Ministry of Science and Art, three scientists from the LMU now received the 2019 award for good teaching
LMU researchers have discovered a novel type of chemical modification in bacterial RNAs. The modification is apparently attached to molecules only when cells are under stress, and is rapidly removed during recovery.

LMU researchers report that a central component of the innate immune response is activated by two short RNAs which are produced by site-specific cleavage of a precursor RNA molecule – and both derivatives are generated by the same enzyme.

On December 30, 2019 there will be the DAY OF RESEARCH AT THE DEPARTMENT OF PHARMACY.

13 LMU faculty members are among the authors listed in “Highly Cited Researchers 2019”. The ranking is based on an analysis of the citation history of scholarly publications, and covers the Natural, Social and Medical Sciences.

Since November 2019, the new SciFinder version Scifindern is available to all members of the LMU for research purposes.

Iridium is an ideal catalyst for the electrolytic production of hydrogen from water – but it is extremely expensive. But now a new kind of electrode made of highly porous material does an excellent job with just a hint of iridium.

Environmentally benign methods for the industrial production of chemicals are urgently needed. LMU researchers recently described such a procedure for the synthesis of formaldehyde, and have now improved it with the aid of machine learning.

This year's graduation ceremony of the Department of Pharmacy - Center for Pharmaceutical Research will take place on Friday, November 29, 2019, starting at 2:15 pm in the Audimax of the Biomedical Center Munich.

Festive event on Friday, 7.12.2018, at 15:15

Professor Rolf Huisgen, Professor Emeritus of Organic Chemistry at the LMU, has been elected as one of the two Citation Laureates in 2019 for the chemistry department of the media company Clarivate.

Before life, there was RNA: Scientists at LMU show how the four different letters of this genetic alphabet could be created from simple precursor molecules on early Earth - under the same environmental conditions.

Using the example of an important industrial process, LMU chemists show that defects on the surface of catalysts are essential for their activity.

Chemical engineers at Ludwig-Maximilians-Universität (LMU) in Munich, Germany, have developed the first molecular motor that enables an eight-shaped movement.

A team of physicists and quantum chemists is the first to measure the transition from a slight atomic bond to a strong one.

As part of the DPHG Annual Meeting 2019, Prof. Angelika Vollmar was awarded the highly prestigious Carl Mannich Medal.

LMU researchers have determined the structure of a key enzyme complex that is involved in DNA repair, and traced the cycle of conformational changes that it undergoes while performing its biochemical function.

Ten early-career researchers have won ERC Starting Grants in conjunction with LMU.

A biosensor´s most important sign of quality is sending a clear color signal when the target molecule binds. The signal strength depends on the distance of the fluorescence molecules involved. Now members of the Cluster of Excellence “e-conversion” are able to define and optimize this distance with nanometer precision.

In coming winter semester 2019/20, a theoretical and practical preparatory course will be held for prospective teaching chemistry students of all types of schools.

Professor Oliver Trapp is supported by the Volkswagen Foundation in his research into the beginning of life.

Professor Julian Stingele has been awarded the Bayer Early Excellence Award by the Bayer Science & Education Foundation.

DNA, the hereditary material, may have appeared on Earth earlier than has been assumed hitherto. LMU chemists led by Oliver Trapp show that a simple reaction pathway could have given rise to DNA subunits on the early Earth.

JGR Seminar at the Faculty of Chemistry and Pharmacy LMU

The Princess Therese of Bavaria Prize this year will also be awarded to two scientists of the Faculty of Chemistry and Pharmacy, Prof. Dr. med. Lena Daumann and Prof. Dr. med. Olivia Merkel.

The LMU has added a central element to its campus Großhadern / Martinsried. The new building, in which researchers investigate important mechanisms of genetic control, is taking shape.

Professor Thomas Carell, holder of the Chair of Organic Chemistry at LMU, has been elected to the Supervisory Board of BASF SE - one of the largest chemical companies in the world.

The cover of the current issue of the journal “Angewandte Chemie” highlights the achievements of the group around Prof. Rasmus Linser, innovating solid-state NMR spectroscopy: Nuclear magnetic resonance (NMR) spectroscopy involving ultra-fast magic angle spinning now enables comprehensive characterization of protein structure and dynamics from only minimal amounts of non-deuterated, solid proteins.

The European Research Council (ERC) has awarded Advanced Grants to three principal investigators at LMU.

In the cooperation project "Our Common Future" between the Department of Chemistry of the Ludwig-Maximilians-University Munich and the Feodor-Lynen-Gymnasium Planegg, students of the 11th grade of the Feodor-Lynen-Gymnasium Planegg examine under the professional guidance of Prof. Lena Daumann and of the Fachdidaktik Chemie, Prof. Stefan Schwarzer, how rare earths can be recovered from everyday objects and recycled in an environmentally friendly way.

Professor Lena Daumann from the Faculty of Chemistry and Pharmacy of the LMU has been awarded the prestigious Ars legendi Faculty Award for her excellent teaching.

LMU chemists have developed a versatile method for the synthesis of highly functionalized thioethers. This building block is widely used in, among other things, biologically active substances.

The German Research Foundation (DFG) has awarded one of its most prestigious honors, the Heinz Maier-Leibnitz Prize, to Professor Henriette Uhlenhaut, an endocrinologist at LMU’s Gene Center.

Am Freitag, den 22.02.2019 findet der jährliche Schüler-Info-Tag 2019 für alle an Chemie oder Pharmazie interessierten Schüler statt. Highlights sind die große Chemievorlesung sowie Führungen, Experimente und Vorträge für Schüler auf dem gesamten Campus. Die Studiengangskoordinatoren stellen die Studiengänge der Fakultät vor.

LMU chemists have identified a mechanism that allows molecules to diffuse rapidly on the already crowded surface of a solid-state catalyst – an important capability, especially for efficient catalysis under industrial conditions.

The LMU and NIM scientist Prof Ernst Wagner coordinates the Working Package “Tailor gene-delivery strategies” within the new EU project “UPGRADE: Unlocking Precision Gene Therapy”. He and Dr. Ulrich Lächelt will optimize the non-viral delivery of new and precise gene-editing tools.